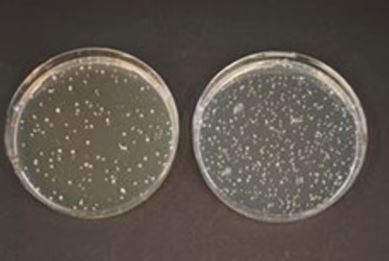

Description
Synonyms: BSC Propionate Agar Base, Bifidobacteria Selective Count Agar Base, TOS-MUP Agar (Base), Transgalctosylated oligiosaccharide agar medium
General description
TOS-propionate agar medium is specifically prepared for selective enumeration of Bifidobacteria in dairy products. Casein hydrolysate and yeast extract provide essential sources of nitrogen and other growth nutrients like vitamin B complex. The medium contains highly purified Galacto-oligosaccharides and sodium propionate that acts as an excellent growth promoting substances for Bifidobacteria. Cysteine hydrochloride helps in creating reduced conditions required for the growth. Ammonium sulphate and magnesium sulphate are a source of divalent cation, nitrogen, and sulphate. Lithium mupirocin is an antimicrobial supplement that inhibits the growth of most lactic acid bacteria, commonly found in fermented and non-fermented dairy products
Application
TOS-propionate agar medium is recommended for enumeration of presumptive Bifidobacteria by colony count technique from milk products.
Preparation Note
Suspend 62.02 grams of dehydrated media in 950 ml distilled water (1 liter fornon-selective media). Heat to boiling to dissolve the medium completely. Sterilize by autoclaving at 115°C for 15 minutes.
For selective isolation of Bifidobacteria add contents of 2 x 25 ml vials of Lithium mupirocin Supplement (Cat. No. 69732). Mix carefully to avoid the formation of air bubbles and dispense as desired.
Note: This medium being sensitive to heat, excessive heat treatment may therefore indicatively influence the properties of the medium. For more selectivity Glacial acetic acid (Bifido Selective Supplement B, Cat. No. 90577) may also be added. After addition of Bifido Selective Supplement B pH of the medium will shift to the acidic side, which does not affect the performance of the medium.
For selective isolation of Bifidobacteria add contents of 2 x 25 ml vials of Lithium mupirocin Supplement (Cat. No. 69732). Mix carefully to avoid the formation of air bubbles and dispense as desired.
Note: This medium being sensitive to heat, excessive heat treatment may therefore indicatively influence the properties of the medium. For more selectivity Glacial acetic acid (Bifido Selective Supplement B, Cat. No. 90577) may also be added. After addition of Bifido Selective Supplement B pH of the medium will shift to the acidic side, which does not affect the performance of the medium.
PROPERTIES
Agency
according to ISO 29981:2010 IDF 220:2010
Pack Size
500g
sterility
non-sterile
form
powder
shelf life
limited shelf life, expiry date on the label
composition
agar, 15 g/L
ammonium sulfate, 3 g/L
casein enzymic hydrolysate, 10 g/L
L-cysteine hydrochloride, monohydrate, 0.5 g/L
dipotassium hydrogen phosphate, 4.8 g/L
Galactooligosaccharide, 10 g/L
magnesium sulfate heptahydrate, 0.2 g/L
Potassium dihydrogen phosphate, 3 g/L
sodium propionate, 15 g/L
yeast extract, 1 g/L
manufacturer/tradename
NutriSelect® Plus
technique(s)
microbiological culture: suitable
final pH
6.3±0.2 (25 °C)
application(s)
food and beverages
microbiology
suitability
Bifidobacterium spp.
Footnote
We offer two media types: the superior granulated GranuCult® and the cost-efficient powdered NutriSelect® culture media, depending on your needs.
The designations basic, plus, or prime are added to indicate the quality control level, from basic quality control to standard QC plus to prime for full regulatory compliance.
The designations basic, plus, or prime are added to indicate the quality control level, from basic quality control to standard QC plus to prime for full regulatory compliance.
Legal Information
GRANUCULT is a registered trademark of Merck KGaA, Darmstadt, Germany
NutriSelect is a registered trademark of Merck KGaA, Darmstadt, Germany

Reviews
There are no reviews yet.